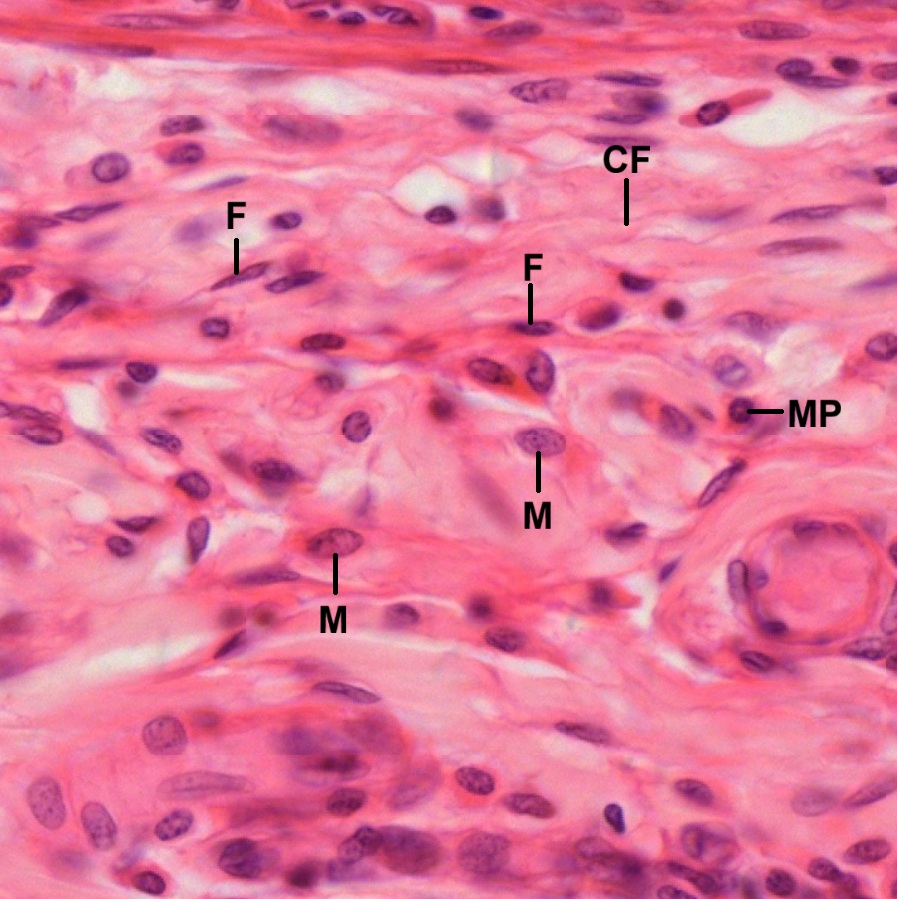

Connective tissues are derived from multipotential mesenchyme . Here we focus on the connective tissue proper which is composed of cells, fibers, and amorphous ground substance. Types of fibers include collagen fibers, reticular fibers, and elastic fibers. It provides structural and metabolic support for other tissues and organs throughout the body. Depending on the cellular components and density of extracellular matrix, adult connective tissues can be divided into: 1) loose connective tissue or areolar tissue; 2) reticular tissue; 3) adipose tissue; 4) dense irregular connective tissue as in the dermis of the skin and capsules of some organs; 5) dense regular connective tissue, composed of collagen fibers as in tendons and ligaments, or elastic fibers as in the ligamentum nuchae, the ligamentum flava, and the suspensory ligament of the penis. The extracellular matrix consists of fibers, amorphous ground substance, and tissue fluid. In developing embryos, connective tissues exist in two forms, mesenchyme and mucous tissue.
Loose Connective Tissue
It is also known as areolar tissue which constitutes much of superficial fascia and surrounds different organs in the human body. By mounting a flattened piece of stained areolar tissue, such as mesentery (Fig. 3-1), on slide, it can be seen to be composed of fibers and cellular elements within the ground substance primarily made up of collagenous and elastic fibers (Fig. 3-2). Collagenous fibers (C) are pale stained wide bands in contrast to dark stained slender-shaped elastic fibers (E). Spindle-shaped cells with tails are seen to be widely dispersed in the tissue (Figs. 3-2 and 3-3). They are fibroblasts (F). The other cells being identified in this preparation are large oval-shaped mast cells (M). Mast cells can be highlighted in a mounting preparation stained by methylene blue (Fig. 3-4). Abundant granules are seen within the cytoplasm.
In a tissue or organ section, such as skin section is used as an example, areolar tissue is found underneath the epithelial layer or epidermis, also known as papillary dermis (Figs. 3-5 and 3-6), which is the thin, upper layer of dermis. It features finger-like projections called dermal papillae, which interlock with the epidermis to create a strong connection and increase surface area. This layer contains loose connective tissue, blood vessels that nourish the skin, nerve endings for touch sensation. The predominant cells are fibroblasts (F). Other cells like mast cells (M), plasma cells (P), and phagocytes (Ph) can also be found. (Fig. 3-7).
Reticular Tissue
Reticular tissue is a type of loose connective tissue composed of a delicate network of reticular fibers, providing a flexible, supportive framework (stroma) for highly cellular organs like lymph nodes, liver, kidney, spleen, and bone marrow. These fibers are produced by specialized fibroblasts known as reticular cells. The mesh-like structure of reticular tissue creates a supportive microenvironment for cells to filter fluids and maintain organ architecture. In sections of lymph node (Fig. 3-8), liver (Fig. 3-9), and kidney (Fig. 3-10) stained by silver impregnation, dark stained reticular cells (R) and reticular fibers (RF) can be seen.
Adipose Tissue
Adipose tissue is a loose connective tissue, also known as fat tissue. There are two kinds of adipose tissues. Visually they are distinguished by colors, white or brown.
White Adipose Tissue
It comprises 20-25% of total body weight in normal adults and mainly in deep layers of skin. In a section of adipose tissue stained by hematoxylin and eosin (Fig. 3-11), many adipocytes (A) are found to form a spiderweb-like organization due to unstained lipid component removed from cytoplasm during preparation (Fig. 3-12). Adipocyte nuclei (N) are squeezed to outer rim of the cytoplasm by these empty vacuoles. Other cells, like preadipocytes (P), Fibroblasts (F), vascular endothelial cells (V) and a variety of immune cells such as adipose tissue macrophages (M), can also be found. The main role of adipose tissue is to store energy in the form of lipids, although it also cushions and insulates the body. In most cases, lipid content of adipocytes is found to fuse into a single large droplet. In certain area of the adipose tissue (Figs. 3-13 and 3-14) it is found that few adipocytes contain small vacuoles of lipid droplets (L). Nuclei (N) of these adipocytes or preadipocytes are not squeezed to outer rim of the cytoplasm by these small vacuoles.
Brown Adipose tissue
It is mainly found in newborn mammals and some hibernating animals and contains a rich supply of mitochondria, which gives it a reddish-brown color. Only small amounts of brown adipose tissue are found in human adults. In a section of brown adipose tissue taken from mouse, stained by HE (Fig. 3-15), it is found that there are more adipocytes containing many small vacuoles than those containing single large vacuoles (Fig. 3-16). At higher magnification (Figs. 3-17 and 3-18), among single vacuoles-containing adipocytes (A) more adipocytes are found to contain small vacuoles inside the cytoplasm. These small vacuoles are lipid droplets (Ld).
Dense Irregular Connective Tissue
It is a type of dense connective tissue characterized by densely packed collagen fibers (CF) arranged in a haphazard, interwoven network, rather than parallel bundles. This structure provides high tensile strength and resistance to forces from multiple directions. It can be found in lower dermis of the skin (Fig. 3-19), the fibrous capsules (FC) of organs like spleen (Fig. 3-20), and the submucosa of the gastrointestinal tract such as jejunum (Fig. 3-21) and ileum (Fig. 3-22). The primary cells are widely spaced fibroblasts (F). Other observable cells include mast cells (M) and macrophages (MP).
Dense Regular Connective Tissue
In contrast to the dense irregular connective tissue, it is a strong fibrous tissue made of densely packed, parallel collagen fibers arranged by fibroblasts. This parallel structure provides high tensile strength and allows the tissue to transfer force in a single direction. Common examples of dense regular connective tissue include tendons (Fig. 3-23) and ligaments (Fig. 3-25). In longitudinal sections of both tissues, densely packed, parallel collagen fibers (CF) arranged by fibroblasts (F) can be seen clearly. In cross section of tendon (Fig. 24), these parallel collagen fibers are observed to be red dots with blue dots of fibroblasts scattered among them. Despite of histological similarity, they play different roles in anatomy. Tendons connect muscle to bone while ligaments connect bone to bone. There is another type of dense regular connective tissue called elastic ligament or yellow elastic ligament (Fig. 3-26). The term includes “elastic” due to its component of elastic fibers which cannot be distinguished from collagen fibers after hematoxylin-eosin staining. The presence of elastic fibers makes elastic ligament to be yellow. It is mainly found to be ligament between vertebrae, called ligamentum flavum (= yellow ligament in English). In term of color, tendon and ligament are collectively known as white fibrous tissue. In contrast, elastic ligament is known as yellow fibrous tissue.
Mesenchyme
Mesenchyme is a type of loosely organized embryonic connective tissue of undifferentiated cells that give rise to most tissues, such as skin, blood, or bone. In a tissue section prepared from developing subcutaneous tissue (Fig. 3-27), mesenchymal cells (M) are found to have an irregular, stellate or fusiform shape with delicate branching cytoplasmic extensions, forming an interlacing network throughout the tissue (Figs. 3-28 and 3-29). The oval nuclei (N) have dispersed chromatin and visible nucleoli. The extracellular material consists almost exclusively ground substance with no mature fibers. A micrograph of mature fibroblasts (F) in loose connective tissue (Fig. 3-30) is shown here for comparison.
Mucous Tissue
The best example of mucous tissue is umbilical cord (Fig. 3-31). It is a gelatinous connective tissue containing stellate cells (S) with long processes (P) in a soft matrix (Fig. 3-32), also known as Wharton’s jelly. In contrast to mesenchyme (Fig. 3-28) which contains no collagen fibers, it has randomly arranged collagen fibers (CF) and fibroblasts (F) with ground substance (Fig. 3-33).
NOTE:
- Only those organelles visible under the light microscope are discussed here. It is suggested that to study all organelles visible under the electron microscope through your histology textbook and atlas.
- All photos used for discussion are taken from DSMH and DSAH digital slides as follows:
H030011 White Fibrous Tissue, cs. of tendon, human, HE. (Fig. 3-24)
H030012 White Fibrous Tissue, ls. of tendon, human, HE. (Fig. 3-13)
H030014 Ligament, ls., human, HE. (Fig. 3-25)
H030020 White Adipose Tissue, sec., human, HE. (Figs. 3-11, 3-12, 3-13, 3-14)
H030022 Brown Adipose Tissue, sec., mouse, HE. (Figs. 3-15, 3-16, 3-17, 3-18)
H030030 Areolar Tissue, wm. of mesentery, human HE. (Figs. 3-1, 3-2, 3-3)
H030031 Mast Cells, wm. of mesentery, mammal, MB. (Fig. 3-4)
H030032 Areolar Tissue, sec., human HE. (Figs. 3-5, 3-6, 3-7, 3-19, 3-30)
H030040 Mucous Tissue, cs. of umbilical cord, human HE. (Figs. 3-31, 3-32, 3-33)
H030050 Reticular Tissue, sec. of lymph node, human SI. (Fig. 3-8)
H030140 Yellow Elastic Ligament, ls., human, HE. (Fig. 3-26)
H030150 Mesenchyme, sec. of developing subcutaneous tissue, human, HE. (Figs. 3-27, 3-28, 3-29)
H070050 Spleen, sec., human, HE. (Fig. 3-20)
H090210 Jejunum, cs., human, HE. (Fig. 3-21)
H090220 Ileum, cs., human, HE. (Fig. 3-22)
H090310 Liver, sec., human, SI. (Fig. 3-9)
H110011 Kidney, sec., human, SI. (Fig. 3-10) - Staining methods and results:
HE = hematoxylin and eosin, is used to stain cell nuclei blue and cytoplasm pink or red. Hematoxylin may also stain ribosomes and rough endoplasmic reticulum blue.
MB = methylene blue, is used to stain rough endoplasmic reticulum blue.
SI = silver impregnation, is used to demonstrate neurons and processes in black or brown.